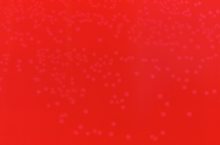

Erysipelothrix rhusiopathiae
| Domaine | Bacteria |
|---|---|
| Embranchement | Firmicutes |
| Classe | Mollicutes |
| Ordre | Anaeroplasmatales |
| Famille | Erysipelotrichidae |
| Genre | Erysipelothrix |
Espèce
(Migula 1900) Buchanan 1918
Erysipelothrix rhusiopathiae est une bactérie à Gram positif en forme de bâtonnet non ramifié (forme régulière). Répandue dans le monde entier, ubiquiste, très résistante dans les sols humides, E. rhusiopathiae a d’abord été considérée comme un agent pathogène pour l’animal chez qui elle est responsable d’un érysipèle. La zoonose transmise par cette bactérie est appelée rouget du porc chez l'humain (ou encore erysipéloïde de Rosenbach, érythème migrateur, érysipélotrichose, ou enfin maladie des poissonniers) ; elle est considérée, en France, comme une maladie professionnelle. Les dindes et les porcs sont les espèces les plus fréquemment atteintes, mais des cas ont été signalés chez d’autres espèces d’oiseaux, des poissons et des reptiles[1].
La maladie humaine appelée érysipèle n’est pas due à E. rhusiopathiae mais à différentes bactéries, des genres Streptocoque et Staphylocoque.
Pathogénie
Chez l’humain les infections à E. rhusiopathiae se présentent le plus souvent sous une forme cutanée atténuée connue sous le nom d’érysipélotrichose. E. rhusiopathie peut provoquer une cellulite (phlegmon) indolore, le plus souvent rencontrée chez les personnes qui manipulent du poisson ou de la viande crue[2]. La contamination se fait généralement par des plaies de la main. La bactériémie et l’endocardite infectieuse sont des complications rares[3],[4]. En raison de la rareté des cas rapportés chez l’humain, les infections à E. rhusiopathie ne sont pas toujours identifiées lors de leur survenue[1].

Caractères bactériologiques
Morphologie
Bacilles immobiles, non ramifiés et très fins (2 µm sur 0,2 à 0,4 µm), Gram positif, anaérobie ou aérobie facultatif. Le bacille peut former des filaments (thrix) de quelques dizaines de µm (aspect en touffe de cheveux).
Culture
Il cultive entre 5 et 44 °C, à pH neutre, est peu exigeant et apprécie une atmosphère enrichie en dioxyde de carbone.
Très petites colonies transparentes de type S de 0,1 mm, α-hémolytiques. Catalase -, Oxydase -, H2S +. Listeria monocytogenes est, à l'inverse, catalase +, H2S -, β-hémolytique et forme des colonies plus grandes.
Peuvent être observées des colonies R liées aux formes filamenteuses. La transition R vers S et S vers R est possible.
La gélose au sang d'isolement peut être rendue sélective par addition d'azide, de cristal violet et de novobiocine comme pour les Enterococcus.
L'identification est possible à l'aide d'une microgalerie comme API Coryne.
Il semble exister une vingtaine de sérovars capsulaires (polyosidiques).
Pouvoir pathogène expérimental
L'inoculation intrapéritonéale à la souris provoque une septicémie rapidement mortelle.
Ce bacille est tué par un chauffage à 70 °C durant 5 à 10 min, ainsi que par des solutions de phénol, de soude ou de crésol.
Facteurs de pathogénicité
Présence d'une capsule thermolabile (au rôle antiphagocytaire)
Présence d'une hyaluronidase et d'une neuraminidase. Cette dernière permettrait l'invasion cellulaire par la bactérie.
Histoire
(d'après Henri Monteil, professeur à l'Institut de bactériologie)
1877 : Un vétérinaire de Bollène (dans le Vaucluse), M. Mancuer, alerte Louis Pasteur sur le mal rouge des porcs ou rouget qui tue plus de 20 000 porcs dans la vallée du Rhône.
vers 1876 à 1880 : Robert Koch isole pour la première fois le bacille à partir d'une souris qui a été injectée par un sang putréfié.
1882 : En mars de cette année-là, il propose à son collaborateur Thuillier d'étudier cette maladie dans la Vienne où elle sévissait particulièrement. Le jeune et remarquable chercheur reconnaît rapidement dans le sang et les humeurs des porcs morts, victimes du rouget, un nouveau microbe qui semblait devoir causer la maladie.
Loeffler cultive le bacille à partir de vaisseaux cutanés du porc.
Le microbe découvert par Thuillier était bien l'auteur de la maladie. Isolé puis inoculé à des porcs, il provoqua leur mort par le mal rouge.
La bactérie est alors appelé Bacillus insidiosus avant de trouver son nom actuel en 1909.
En novembre 1882, Pasteur en compagnie de Thuillier (qui meurt un peu plus tard du choléra à Alexandrie lors d'un mission contre le choléra, dirigée par Roux) et de Loir (aide préparateur), se rend à Bollène. M. Mancuer lui fait faire le tour des porciers du canton.
Après avoir atténué la virulence du microbe par des passages successifs chez les lapins, (où au contraire la virulence est exaltée) il obtient un vaccin utilisable chez les porcelets en dessous de 4 à 5 mois. Les vaccinés furent soumis pendant un an à la surveillance du vétérinaire.
1883 : Le 4 septembre 1883, MANCUER écrivait à PASTEUR : "Il n'y aura bientôt plus à Bollène, à Saint Restitut, à Mondragon et dans tout l'arrondissement d'Orange que les porcs vaccinés qui demeurent vivants. C'est une réussite complète". Le conseil municipal de Bollène vota une motion de reconnaissance à Pasteur.
Diagnostic
Assez difficile : la culture doit se faire à partir d'une petite biopsie pratiquée au bord de la lésion.
Clinique
(de la version anglaise de l'article)
Humains
Chez l'humain, les infections à E. rhusiopathiae se présentent le plus souvent sous une forme cutanée bénigne appelée érysipéloïde[5]. Plus rarement, cela peut entraîner une septicémie; ce scénario est souvent associé à une endocardite. L'érysipéloïde, également nommé par le passé, maladie de Rosenbach, maladie de Baker – Rosenbach et pseudoérysipèle, est une infection bactérienne de la peau causée par une pénétration traumatique d'E. rhusiopathiae[5].
Elle survient le plus souvent en tant que maladie professionnelle. La maladie se caractérise cliniquement par un œdème érythémateux, avec des bordures bien définies et surélevées, généralement localisées au dos d'une main et / ou des doigts. Les paumes, les avant-bras, les bras, le visage et les jambes sont rarement impliqués. Des lésions vésiculaires, bulleuses et érosives peuvent également être présentes. La lésion peut être asymptomatique ou accompagnée d'un léger prurit, de douleur et de fièvre.
Animaux
Erysipelothrix rhusiopathiae peut infecter un large éventail d'animaux, avec ou sans provoquer la maladie clinique que les animaux appellent l'érysipèle.
Les cochons
Chez les porcs, trois formes d'érysipèle peuvent être observées; aiguë, subaiguë ou chronique. La forme aiguë se caractérise par une forte fièvre, une anorexie, une dépression et la mort d'un ou plusieurs animaux. En outre, des lésions cutanées en forme de losange peuvent être observées, elles sont pathognomoniques pour l'érysipèle chez les porcs. Au cours de l'érysipèle subaigu, des signes similaires mais plus légers que dans la forme aiguë sont observés. La forme chronique peut résulter de cas aigus ou subaigus ou d'infections subcliniques. La forme chronique est principalement caractérisée par l'arthrite, mais des morts subites, dues à des lésions valvulaires du cœur, peuvent survenir. Il y aurait de nombreux animaux porteurs asymptomatiques.
La volaille
La bactérie a été isolée d'un large éventail d'espèces aviaires et des différences de sensibilité selon les espèces ont été suggérées. Des flambées d'érysipèle ont été signalées dans presque toutes les espèces de volaille. Historiquement, l'érysipèle a été considéré comme une maladie d'importance significative principalement chez les dindes[6]. Cependant, un nombre croissant de foyers dans des troupeaux de poules pondeuses ont été signalés dans plusieurs pays[7]. Les signes observés lors d'une épidémie d'érysipèle dans un troupeau de poules pondeuses comprennent un début soudain de mortalité élevée et des pertes de production d'œufs[8].
Bœuf musqué
En raison de la chasse non réglementée du bœuf musqué, l'espèce a presque disparu à la fin du XIXe siècle. Cependant, en 1917, des règlements étaient en place et les troupeaux ont commencé à se rétablir à un point tel que la chasse réglementée était autorisée dans les années 1980. Dans les années 1990, les chasseurs étaient autorisés à prendre 10 000 bœufs musqués sur l'île Banks uniquement et en 2001, on estimait qu'il y avait plus de 68 000 bœufs musqués sur l'île, ce qui en faisait la plus grande population du monde. Cependant, depuis lors, les chiffres ont chuté de 70 % en raison d'Erysipelothrix rhusiopathiae[9],[10].
Prophylaxie
Vaccination des porcs (voir historique).
Traitement
La bactérie est très sensible aux β-lactamines, en particulier la Pénicilline G (les macrolides sont utilisés en cas d'allergie).
Elle résiste aux aminosides, à la colistine et à l'acide nalidixique (mais non aux quinolones de deuxième génération) comme les coques Gram + catalase - (absence de chaine respiratoire) et à la novobiocine.
Législation en France
Voir aussi
Le rouget du porc, Louis-Michel-Emmanuel L'Hostis, Ed du Nord, Paris 1927.
Notes et références
- 1 2 C. Brooke et T. Riley, « Erysipelothrix rhusiopathiae: bacteriology, epidemiology and clinical manifestations of an occupational pathogen », J Med Microbiol, vol. 48, no 9, , p. 789-99 (PMID 10482289)
- ↑ L. Lehane et G. Rawlin, « Topically acquired bacterial zoonoses from fish: a review », Med J Aust, vol. 173, no 5, , p. 256-9 (PMID 11130351)
- ↑ P. Brouqui et D. Raoult, « Endocarditis due to rare and fastidious bacteria », Clin Microbiol Rev, vol. 14, no 1, , p. 177-207 (PMID 11148009)
- ↑ I. Nassar, R. de la Llana, P. Garrido et R. Martinez-Sanz, « Mitro-aortic infective endocarditis produced by Erysipelothrix rhusiopathiae: case report and review of the literature », J Heart Valve Dis, vol. 14, no 3, , p. 320-4 (PMID 15974525)
- 1 2 S. Veraldi, V. Girgenti, F. Dassoni et R. Gianotti, « Erysipeloid: a review », Journal of Clinical and Experimental Dermatology, vol. 34, no 8, , p.859–862 (PMID 19663854, DOI 10.1111/j.1365- 2230.2009.03444.x, lire en ligne).
- ↑ Bricker JM & Saif YM, editor-in-chief, David E. Swayne ; associate editors, John R. Glisson ... [et (2013). Diseases of poultry (13th ed.). Ames, Iowa: John Wiley & Sons. pp. 986–994. (ISBN 978-0-470-95899-5).
- ↑ Eriksson, Helena; Bagge, Elisabeth; Båverud, Viveca; Fellström, Claes; Jansson, Désirée S. (22 April 2014). "contamination in the poultry house environment during erysipelas outbreaks in organic laying hen flocks". Avian Pathology. 43 (3): 231–237. DOI 10.1080/03079457.2014.907485. .
- ↑ Eriksson, Helena; Brännström, Sara; Skarin, Hanna; Chirico, Jan (10 December 2010). "Characterization of isolates from laying hens and poultry red mites (…) from an outbreak of erysipelas". Avian Pathology. 39 (6): 505–509. DOI 10.1080/03079457.2010.518313. (h.gov/21154061).
- ↑ Gunn, A.; Forchhammer, M. (2008). "Ovibos moschatus (errata version published in 2016)". IUCN Red List of Threatened Species. IUCN. 2008: e.T29684A86066477. Retrieved 24 December 2019.
- ↑ "Banks Island Migratory Bird Sanctuary No. 2". Parks Canada. Retrieved 2020-01-01.
Liens externes
- (en) Catalogue of Life : Erysipelothrix rhusiopathiae (Migula 1900) Buchanan 1918 (Approved Lists 1980)
- (en) NCBI : Erysipelothrix rhusiopathiae (taxons inclus)
- Dictionnaire de Bactériologie vétérinaire
- Abrégé de bactériologie médicale
- Erysipélothrix
- Dossier PDF Rouget du porc
- Dossier zoonoses de l'INRS
- Pathologies d’inoculation dossier PDF
- Pathologies d’inoculation Faculté de Grenoble
- Erysipèle Erysipéloïde
- Fiche CNRS
- Aspects Cliniques
- Louis Thuillier
- Emmanuel Leclainche
- Portail de la microbiologie
- Portail de la biochimie